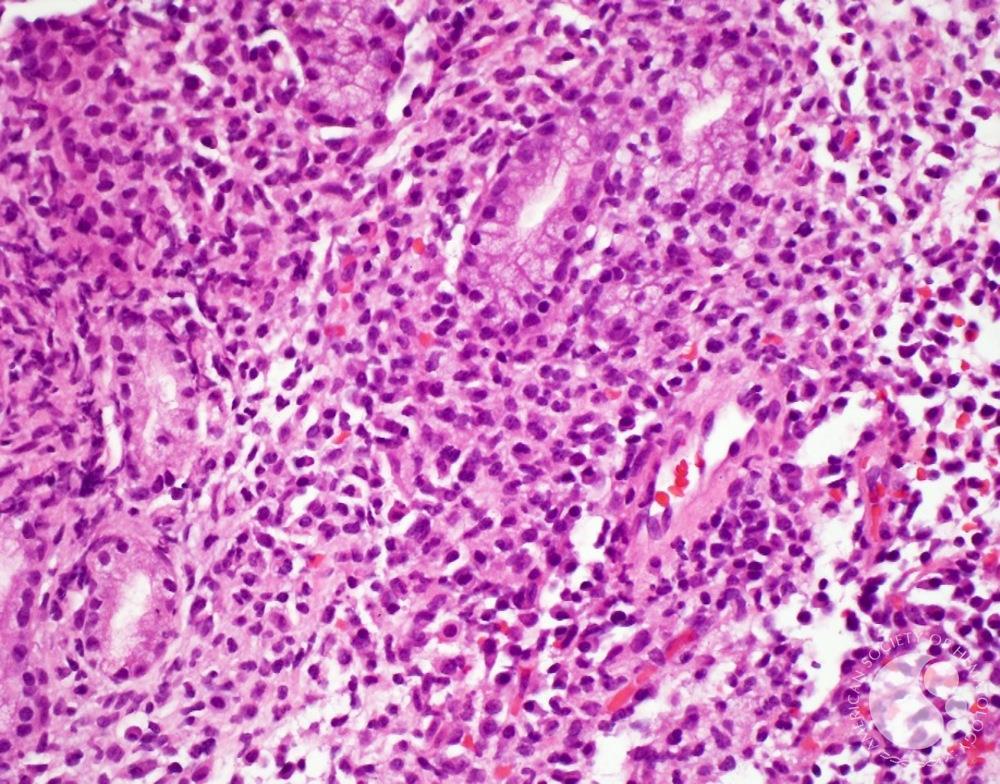
A woman with red hair and a black sleeveless top smiling confidently in a bright, modern indoor setting.

A new generation of local therapeutics that delivers potent immune activation to brain tumors without the risks of systemic exposure.
Our Partners



Pioneering safe, effective, and targeted biological treatments for incurable brain diseases, starting with Glioblastoma.
We engineer compartment-locked cytokines to safely treat glioblastoma and other CNS diseases, realising truly local and exclusive brain treatment for the first time.
Superior Data
Our lead asset, InC01, achieves what systemic* or gene-based IL-12 therapies could not – potent, localised immune activation with complete safety and dosing control.
30%
longterm responders at terminal disease instead of 0% compared to unmodified IL-12 and significantly increased survival in checkpoint resistant murine GBM (Beffinger et al, 2025)
40x
less IFNγ blood overall exposure (AUC) compared to unmodified IL-12 during treatment (Beffinger et al, 2025)
25x
of the therapeutic dose (Beffinger et al, 2025) is still tolerated without systemic toxicity (Preclinical GLP tox)
*via the vascular route, which often only activates perivascular
T-cells and causes unwanted systemic side effects
From Cold to Hot
"Glioblastoma contains dormant immune cells waiting for a signal. Our compartment-locked therapy provides that specific trigger locally, reactivating the patient’s own T-cells without the severe risks of systemic exposure."

Dr. Johannes vom Berg
CSO & Co-Founder
Glioblastoma remains one of the most aggressive cancers, with a median survival of just 12–15 months and few effective treatment options. We have secured EMA Orphan Drug Designation, validating the urgent need for new glioblastoma treatments. This status grants us ten years of market exclusivity and key regulatory incentives, securing a protected commercial pathway to deliver this life-saving therapy.
241,000
People die from GBM each year
25
Patients in our upcoming Phase I/IIa trial.
2027
Targeted first-in-human clinical readouts.
Leadership
If you have further questions, please reach out via our Contact form.
Whether you are a clinical partner joining our European trial network or an investor ready to back a high-value orphan asset, don't hesitate to reach out.
* Add any required disclaimer text for the claims made above using this small fine-print text.
Main Office
office@incephalo.com
Office and Laboratory
Wagistrasse 21
8952 Schlieren
Switzerland
office@incephalo.com